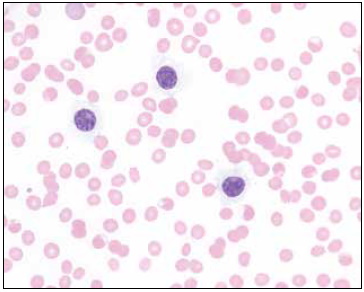
Figure 1

A 70-year-old man presented with altered mental status and generalized weakness. Imaging showed mild splenomegaly and a 4.6 cm confluent soft tissue mass in the retroperitoneum interposed between the aorta, inferior vena cava, and portal vein, and encasing the right renal artery and right renal vein. Laboratory evaluation was significant for the following:
| . | Value (Reference Range) . |
|---|---|
| White blood cell count | 20.5 × 103/μL (3.4-10.0 × 103/μL) |
| Neutrophils | 0.82 × 103/μL (1.8-6.8 × 103/μL) |
| Lymphocytes | 19.68 × 103/μL (1.0-3.4 × 103/μL) |
| Monocytes | 0 × 103/μL (0.2-0.8 × 103/μL) |
| Eosinophils | 0 × 103/μL (0-0.4 × 103/μL) |
| Basophils | 0 × 103/μL (0- 0.1 × 103/μL) |
| Hemoglobin | 8.0 g/dL (13.6-17.5 g/dL) |
| Platelet count | 20 × 103/μL (140-450 × 103/μL) |
| . | Value (Reference Range) . |
|---|---|
| White blood cell count | 20.5 × 103/μL (3.4-10.0 × 103/μL) |
| Neutrophils | 0.82 × 103/μL (1.8-6.8 × 103/μL) |
| Lymphocytes | 19.68 × 103/μL (1.0-3.4 × 103/μL) |
| Monocytes | 0 × 103/μL (0.2-0.8 × 103/μL) |
| Eosinophils | 0 × 103/μL (0-0.4 × 103/μL) |
| Basophils | 0 × 103/μL (0- 0.1 × 103/μL) |
| Hemoglobin | 8.0 g/dL (13.6-17.5 g/dL) |
| Platelet count | 20 × 103/μL (140-450 × 103/μL) |
A peripheral blood smear showed lymphocytosis consisting of small to intermediate-sized cells (Figure 1). Bone marrow aspirate smears contained cellular spicules that showed abundant cells that were morphologically similar to those seen in the peripheral blood (Figure 2). The core biopsy showed a hypercellular marrow (~85% cellularity) infiltrated by sheets of monotonous lymphocytes that by immunohistochemical stains (IHCs) were positive for CD20, cyclin D1/BCL1, and annexin A1 (Figure 3). Flow cytometric immunophenotyping detected a λ-restricted B-cell population expressing bright CD20, weak CD25, variable CD103, and CD200, without co-expression of CD5, CD10, or CD123 (Figure 4). Additional IHCs were informative, and molecular studies were also confirmatory.
What is the diagnosis?
Splenic marginal zone lymphoma
Hairy cell leukemia
Hairy cell leukemia variant
Mantle cell lymphoma
For the solution to the quiz, visit The Hematologist online, https://ashpublications.org/thehematologist/pages/an_unusual_case_of_lymphocytosis.
Competing Interests
Dr. Levine, Dr. Chen, and Dr. Prakash indicated no relevant conflicts of interest.